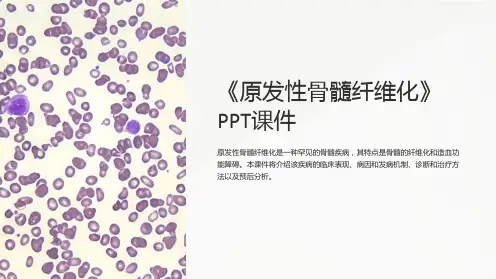

发病年龄50-70岁(中位年龄65岁)少数病例会出现幼小 儿童
男女发病率相似
Pathol Biol(Paris),2001,49:164-166. Acta Haematol,1991,85:124-127.
临床表现
本病中位年龄60岁,起病缓慢,早期可无症状(30%)或
仅表现为乏力多汗、消瘦、体重减轻和脾肿大引起上腹憋 闷。
严重者可有骨痛、发热、出血,高尿酸血症(肾结石、痛 风性关节炎),胸腹水、瘙痒、也有合并肝硬化。
巨脾是本病突出体征之一 1cm/年
骨髓纤维化导致 骨髓窦变形,不成熟的 造血干细胞进入窦内, 随血流进入外周血,种 植在髓外造血部位。脾组织的髓外源自血,巨核细胞易见相关检查(1)
贫血 脾功能亢进,红细胞破坏
Leukemia,2008,22:1299-307
JAK-STAT信号途径
能够激活 JAK2激酶 的受体包 括:EPOR,TPOR,GMCSFR,IL3R,gp130 受体家族 等。
Genetic and epigenetic complexity in myeloproliferative neoplasms. Hematology
Tefferi A and Vardiman JW.Classification and diagnosis of myeloproliferative neoplasms: The 2008 World Health Organization criteria and point-of-care diagnostic algorithms. Leukemia 2008, 22, 14–22
– 正常细胞含G6PD同功酶A,有些为B,MF只有一种G6PD同功酶,提 示来自一个干细胞克隆。